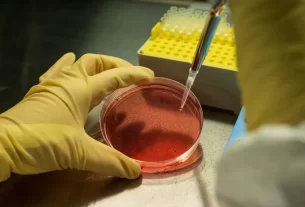

Un video compartido en redes sociales este jueves muestra cómo un iceberg gigante se desintegró en pocos segundos, mientras sus pedazos se hundían en el mar. Las imágenes fueron grabadas en la costa de la provincia canadiense de Terranova y Labrador.